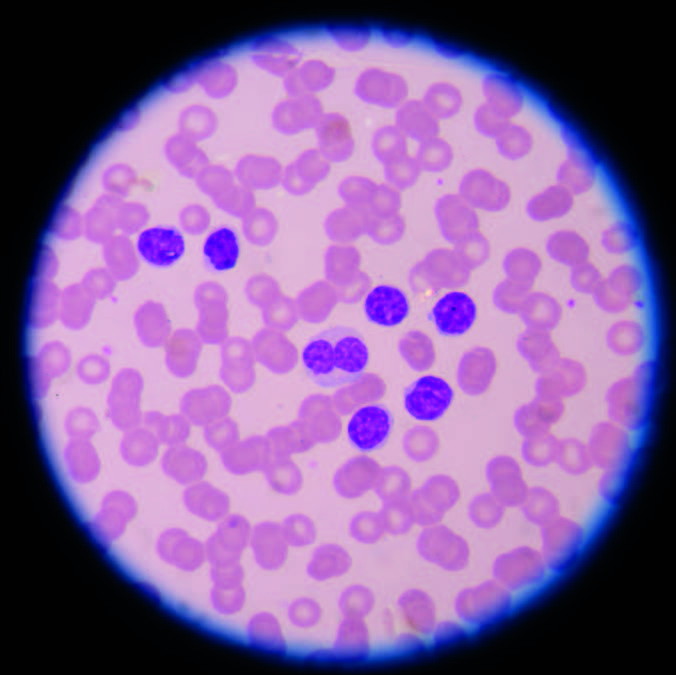

CAR T-Cell Therapy for Childhood Brain Tumours
A Nature Medicine-published breakthrough in treating the most common malignant brain tumour in children - funded from its earliest stages by OHCF.
Read moreOlivia Hodson died from a malignant germ cell tumour in 1996. She was two and a half years old. The following year her family established the Olivia Hodson Cancer Fund to ensure that no family would face the same outcome if research could prevent it.
Since then, the fund has channelled over £3.5 million into paediatric cancer research and palliative care at Great Ormond Street Hospital and the UCL Institute of Child Health.
This is Olivia
The Olivia Hodson Cancer Fund supports paediatric cancer research, treatment, nursing care and family wellbeing at Great Ormond Street Hospital and the UCL Institute of Child Health. We fund projects across oncology, haematology and bone marrow transplants -from pioneering immunotherapy in the lab to helping children stay active through treatment.
We focus particularly on early-stage work that is too small or too novel to attract funding from larger grant-giving bodies. That pump-priming role is at the heart of what we do: a modest OHCF grant can generate the preliminary data a researcher needs to unlock millions in follow-on funding.
Every member of our team is a volunteer. We have no administration costs and no overheads. When you give to OHCF, 100% of your donation goes directly to the people working to improve the lives of children with cancer.
Grants given
Projects funded
Goes to projects, no admin costs
We support projects across the full spectrum of childhood cancer -from laboratory research to treatment innovation to the day-to-day experience of children and families.
Laboratory and clinical research into childhood cancers and blood disorders -often the early-stage work that generates the data needed to secure larger grants.
Developing and testing novel approaches to treatment including immunotherapy and drug repositioning.
Supporting specialist nursing care and palliative services for children undergoing treatment.
Funding specialist equipment for more effective diagnosis and treatment of childhood cancers.
Supporting children and families through treatment and beyond -from staying active to managing the emotional impact of a cancer diagnosis.
Since 1997 we have funded over 100 projects at Great Ormond Street Hospital and the UCL Institute of Child Health - from pioneering immunotherapy research to helping children stay active through treatment. Here are some highlights.

A Nature Medicine-published breakthrough in treating the most common malignant brain tumour in children - funded from its earliest stages by OHCF.
Read more
Developing a way to use modified immune cells against childhood AML - a cancer where survival rates have barely improved in twenty years.
Read more
Finding hidden cancer-fighting properties in drugs that already exist - a faster and cheaper route to new treatments.
Read more
A day of sport and fun for children going through cancer treatment - now in its ninth year and bigger than ever.
Read more
A simple idea with big impact - scented breathing masks that turn a frightening moment into something a child can control.
Read more
Tracking how individual brain tumour cells evolve under treatment - to understand why 30% of children with medulloblastoma relapse.
Read moreVolunteer-run. Expert-led.

Christiane Hodson
Founder & Chair

Jill Bryce
Committee

Allie Fitzpatrick
Committee

Suzannah Jackson
Committee

Danni Lawson
Committee

Sarah Peacock
Committee

Shelly Peat
Committee

Phil Ancliff
Chair
Consultant, Paediatric Haematology, GOSH

Anne Anton
Programme Administrator

Allie Fitzpatrick
Advisor and Supporter

Christiane Hodson
Founder

Tom Hodson
Olivia's Brother

Mette Jorgensen
Consultant Oncologist, GOSH

Eddie Lawson
Advisor and Supporter

David O'Connor
Consultant, Paediatric Haematology, GOSH

Henry Purcell
Consultant Cardiologist, Brompton Hospital

Owen Williams
Lecturer, UCL ICH
All donations are administered by Great Ormond Street Hospital Children's Charity (Charity No. 1160024). 100% goes directly to projects.
Donate onlinePhone
020 7905 2235Address
UCL Great Ormond Street Institute of Child Health
30 Guilford Street, London WC1N 1EH